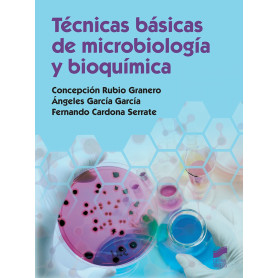
TECNICAS BASICAS DE MICROBIOLOGIA Y BIOQUIMICA  JEYJO

9788468214702 EP 5 - MATEMATICAS CUAD - AULA ACTIVA VICENS (T25)
LIBROS TEXTO
Hay 19191 productos.
9788490773758 DIDACTICA DE LA LENGUA Y LA LITERATURA EDUCACION INFANTIL
Sin Stock
DIDACTICA DE LA LENGUA Y LA LITERATURA EDUCACION INFANTIL Autor: VV.AA.
31,00 €
9788490773765 DIDACTICA DE LA EDUCACION FISICA EN EDUCACION INFANTIL
Sin Stock
DIDACTICA DE LA EDUCACION FISICA EN EDUCACION INFANTIL Autor: VV.AA.
27,50 €
9788490773772 INTRODUCCION A LA PSICOMOTRICIDAD
Sin Stock
INTRODUCCION A LA PSICOMOTRICIDAD Autor: VV.AA.
23,50 €
9788490773864 PROMOCION DE LA AUTONOMIA PERSONAL OTROS
Sin Stock
PROMOCION DE LA AUTONOMIA PERSONAL Autor: Martín Herrero, Macarena
34,00 €
9788490773871 TECNOLOGIA DE LOS MATERIALES EN INGENIERIA VOL.I
Sin Stock
TECNOLOGIA DE LOS MATERIALES EN INGENIERIA VOL.I Autor: VV.AA.
0,00 €
9788490773956 PSICOLOGIA DE LA COMUNICACION LINGÜÍSTICA OTROS
Sin Stock
PSICOLOGIA DE LA COMUNICACION LINGÜÍSTICA Autor: CORTES, MONTSERRAT
31,00 €
9788490774007 MANUAL DE COMUNICACION ESCRITA EN CEREMONIAL Y PROTOCOLO
Sin Stock
MANUAL DE COMUNICACION ESCRITA EN CEREMONIAL Y PROTOCOLO Autor: Casal Maceiras, María Olga
29,50 €
9788490774083 LAS IDEAS POLITICAS Y SOCIALES EN LA EDAD MODERNA OTROS
Sin Stock
LAS IDEAS POLITICAS Y SOCIALES EN LA EDAD MODERNA Autor: VV.AA.
25,00 €
9788490774168 POLITICA EXTERIOR DE GYULA ANDRASSY
Sin Stock
POLITICA EXTERIOR DE GYULA ANDRASSY Autor: VV.AA.
0,00 €
9788490774212 HISTORIA MILITAR DE LA EUROPA MODERNA
Sin Stock
HISTORIA MILITAR DE LA EUROPA MODERNA Autor: VV.AA.
0,00 €
9788490774243 ASENTAMIENTOS Y PAISAJES RURALES EN EL OCCIDENTE MEDIEVAL
Sin Stock
ASENTAMIENTOS Y PAISAJES RURALES EN EL OCCIDENTE MEDIEVAL Autor: VV.AA.
27,50 €
9788490774298 TECNICAS DE ORGANIZACION DE EVENTOS
Sin Stock
TECNICAS DE ORGANIZACION DE EVENTOS Autor: VV.AA.
23,50 €
9788490774304 HISTORIA ACTUAL DEL MUNDO
Sin Stock
HISTORIA ACTUAL DEL MUNDO Autor: RUEDA LAFFOND, JOSE CARLOS/SANCHEZ ROMAN, JOSE ANT
29,50 €
9788490774342 MANUAL DE ORGANIZACION DE ACTOS OFICIALES Y EMPRESARIALES
Sin Stock
MANUAL DE ORGANIZACION DE ACTOS OFICIALES Y EMPRESARIALES Autor: VV.AA.
27,50 €
9788490774519 MANUAL PRACTICO DE REDACCION PERIODISTICA
Sin Stock
MANUAL PRACTICO DE REDACCION PERIODISTICA Autor: VV.AA.
31,00 €
9788490774526 HUMANISMO Y SOCIEDAD DEL RENACIMIENTO
Sin Stock
HUMANISMO Y SOCIEDAD DEL RENACIMIENTO Autor: VV.AA.
27,50 €
9788490774533 DIDACTICA DE LA LENGUA Y LA LITERATURA ESO
Sin Stock
DIDACTICA DE LA LENGUA Y LA LITERATURA ESO Autor: VV.AA.
27,50 €
0,00 €
9788490774564 CIUDAD Y FIESTA: CULTURA REPRESENTACION SOCIEDAD MEDIEVAL
Sin Stock
CIUDAD Y FIESTA: CULTURA REPRESENTACION SOCIEDAD MEDIEVAL Autor: VV.AA.
29,50 €
9788490774588 NUEVO TRATAMIENTO PSICOLOGICO DEL PANICO Y LA AGORAFOBIA
Sin Stock
NUEVO TRATAMIENTO PSICOLOGICO DEL PANICO Y LA AGORAFOBIA Autor: VV.AA.
27,50 €
9788490774601 Gestión de montes OTROS
Sin Stock
Gestión de montes Autor: Lozano Merino, Francisco Carlos
45,97 €
9788490774656 TEORIA E HISTORIA DEL CARTEL PUBLICITARIO
Sin Stock
TEORIA E HISTORIA DEL CARTEL PUBLICITARIO Autor: VV.AA.
27,50 €
9788490774779 TECNICAS BASICAS DE MICROBIOLOGIA Y BIOQUIMICA
Sin Stock
TECNICAS BASICAS DE MICROBIOLOGIA Y BIOQUIMICA Autor: VV.AA.
47,50 €
9788490774809 Laboratorio de prótesis dentales OTROS
Sin Stock
Laboratorio de prótesis dentales Autor: Fuertes Dopico, Eva María
37,86 €
37,86 €
9788490774892 Empresa e iniciativa emprendedora OTROS
Sin Stock
Empresa e iniciativa emprendedora Autor: Vendrell, Efraim;Vallés, Agustí
52,73 €
9788490774915 ESTRUCTURA ACTUAL DEL MERCADO TURISTICO
Sin Stock
ESTRUCTURA ACTUAL DEL MERCADO TURISTICO Autor: VV.AA.
31,00 €
29,50 €
9788490774946 EXPLORACION DE LA CAVIDAD ORAL UNIVERSIDAD
Sin Stock
EXPLORACION DE LA CAVIDAD ORAL Autor: VV.AA.
47,50 €
39,21 €
9788490774991 INFORMACIÓN JUVENIL CICLOS FORMATIVOS
Sin Stock
INFORMACIÓN JUVENIL Autor: Arcos Torrijos, Rosa
31,00 €
9788490785133 Servicio de atención comercial. Grado medio. Comercio y marketing CICLOS FORMATIVOS
Sin Stock
Servicio de atención comercial. Grado medio. Comercio y marketing Autor: VV.AA
41,91 €
9788490785195 Nivel II. Ambito cientifico tecnológico. Diversificación 2 CICLO ESO (3 -4 ESO)
Sin Stock
Nivel II. Ambito cientifico tecnológico. Diversificación Autor: VV.AA
47,32 €
9788490785201 Nivel II. Lengua castellana y literatura. Ambito comunicación ADULTOS.EDUCACION ADULTOS
Sin Stock
Nivel II. Lengua castellana y literatura. Ambito comunicación Autor: VV.AA
41,91 €
9788490785218 Nivel II. Lengua inglesa. Ambito comunicación ADULTOS.EDUCACION ADULTOS
Sin Stock
Nivel II. Lengua inglesa. Ambito comunicación Autor: VV.AA
25,75 €
9788490785225 Nivel II. Ambito social ADULTOS.EDUCACION ADULTOS
Sin Stock
Nivel II. Ambito social Autor: VV.AA
41,91 €
9788490812105 ¿ESPAÑOL? ¡POR SUPUESTO! 1 ESPAÑOL PARA EXTRANJEROS
Sin Stock
¿ESPAÑOL? ¡POR SUPUESTO! 1 Autor: Palomino Brell, María Ángeles
19,76 €
9788490812198 ¿ESPAÑOL? ¡POR SUPUESTO! 1 EJERCICIOS ESPAÑOL PARA EXTRANJEROS
Sin Stock
¿ESPAÑOL? ¡POR SUPUESTO! 1 EJERCICIOS Autor: AA.VV.
8,75 €
9788490813003 Vente 3. Libro Alumno ESPAÑOL PARA EXTRANJEROS
Sin Stock
Vente 3. Libro Alumno Autor: Marin, Fernando
26,00 €
9788490813102 Embarque 3 libro del alumno ESPAÑOL PARA EXTRANJEROS
Sin Stock
Embarque 3 libro del alumno Autor: Alonso Cuenca, Montserrat
24,90 €
9,36 €
9788490814628 Experiencias 12 (B2). Libro del alumno ESPAÑOL PARA EXTRANJEROS
Sin Stock
Experiencias 12 (B2). Libro del alumno Autor: Alonso Arija, Eugenia
9,60 €